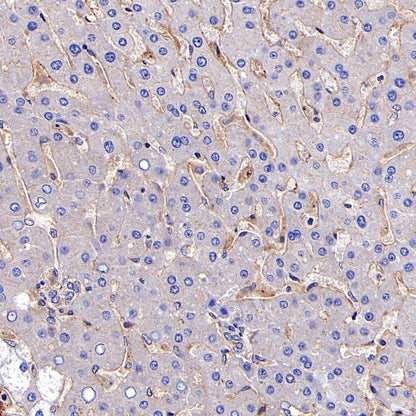
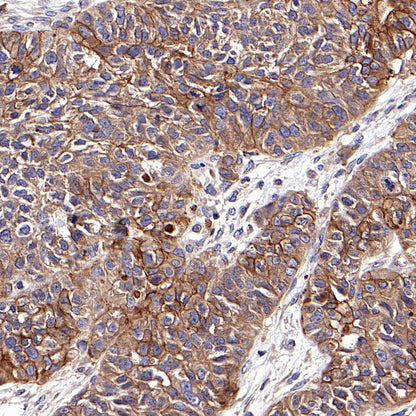

Product Specification
| Host |
Rabbit |
| Antigen |
CD47 |
| Synonyms |
Leukocyte surface antigen CD47, IAP, MER6 |
| Immunogen |
N/A |
| Location |
Cell membrane |
| Accession |
Q08722 |
| Clone Number |
SDT-R121 |
| Antibody Type |
Rabbit mAb |
| Application |
WB, IHC-P |
| Reactivity |
Hu |
| Purification |
Protein A |
| Concentration |
0.5 mg/ml |
| Physical Appearance |
Liquid |
| Storage Buffer |
PBS, 40% Glycerol, 0.05% BSA, 0.03% Proclin 300 |
| Stability & Storage |
12 months from date of receipt / reconstitution, -20 °C as supplied |
Dilution
| application |
dilution |
species |
| WB |
1:1000 |
null |
| IHC-P |
1:200 |
null |
Background
The transmembrane protein, CD47, is recognized as an important innate immune checkpoint, and CD47-targeted drugs have been in development with the aim of inhibiting the interaction between CD47 and the regulatory glycoprotein SIRPα, for antitumor immunotherapy. Further, CD47 mediates other essential functions such as cell proliferation, caspase-independent cell death (CICD), angiogenesis and other integrin-activation-dependent cell phenotypic responses when bound to thrombospondin-1 (TSP-1) or other ligands. Mounting strategies that target CD47 have been developed in pre-clinical and clinical trials, including antibodies, small molecules, siRNAs, and peptides, and some of them have shown great promise in cancer treatment [PMID: 35931392].